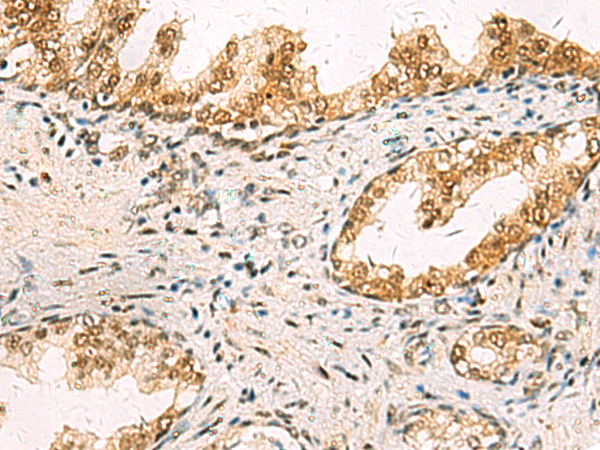
一抗

中文名稱: 兔抗MAPK8多克隆抗體
英文名稱: Anti-MAPK8 rabbit polyclonal antibody
別 名: JNK, JNK1, PRKM8, SAPK1, JNK-46, JNK1A2, SAPK1c, JNK21B1/2
抗 原: MAPK8
儲 存: 冷凍(-20℃)
宿 主: Rabbit
相關(guān)類別: 一抗
反應(yīng)種屬: Human, Mouse, Rat
標(biāo) 記 物: Unconjugate
克隆類型: rabbit polyclonal
技術(shù)規(guī)格
|
Background: |
The protein encoded by this gene is a member of the MAP kinase family. MAP kinases act as an integration point for multiple biochemical signals, and are involved in a wide variety of cellular processes such as proliferation, differentiation, transcription regulation and development. This kinase is activated by various cell stimuli, and targets specific transcription factors, and thus mediates immediate-early gene expression in response to cell stimuli. The activation of this kinase by tumor-necrosis factor alpha (TNF-alpha) is found to be required for TNF-alpha induced apoptosis. This kinase is also involved in UV radiation induced apoptosis, which is thought to be related to cytochrom c-mediated cell death pathway. Studies of the mouse counterpart of this gene suggested that this kinase play a key role in T cell proliferation, apoptosis and differentiation. Several alternatively spliced transcript variants encoding distinct isoforms have been reported. |
|
Applications: |
ELISA, WB, IHC |
|
Name of antibody: |
MAPK8 |
|
Immunogen: |
Fusion protein of human MAPK8 |
|
Full name: |
mitogen-activated protein kinase 8 |
|
Synonyms: |
JNK; JNK1; PRKM8; SAPK1; JNK-46; JNK1A2; SAPK1c; JNK21B1/2 |
|
SwissProt: |
P45983 |
|
ELISA Recommended dilution: |
5000-10000 |
|
IHC positive control: |
Human prostate cancer and Human liver cancer |
|
IHC Recommend dilution: |
50-200 |
|
WB Predicted band size: |
48 kDa |
|
WB Positive control: |
Jurkat, K562, Hela, A172 cell, Mouse brain tissue lysates |
|
WB Recommended dilution: |
500-2000 |



 購物車
購物車 幫助
幫助
 021-54845833/15800441009
021-54845833/15800441009